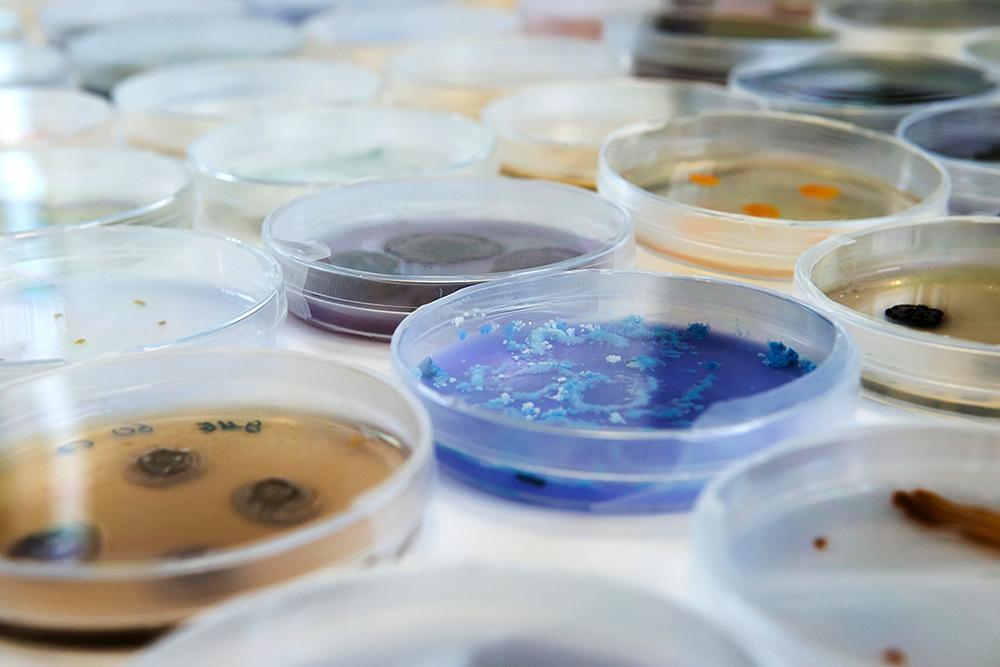

Im Boden wimmelt es von Leben! Mikroben wie Pilze und Bakterien besiedeln nicht nur die Erde, sondern auch Pflanzen – doch sind sie Freund oder Feind? Manche verdauen abgestorbene Pflanzenteile oder lösen Krankheiten aus. Andere hingegen helfen Pflanzen, indem sie Nährstoffe bereitstellen und sie vor Schädlingen oder Trockenheit schützen. Angesichts des Klimawandels und der häufigeren Dürren ist es gut zu wissen, dass bestimmte nützliche Bodenmikroben Pflanzen helfen können, besser mit Wassermangel zurechtzukommen.
Unser Team zeigt euch, dass Bakterien Pflanzen vor Trockenstress bewahren können, am Beispiel der Gerste. Außerdem könnt ihr eine faszinierende Mikrobensammlung entdecken – und mit dem Mikroskop selbst in diese normalerweise unsichtbare Welt eintauchen!